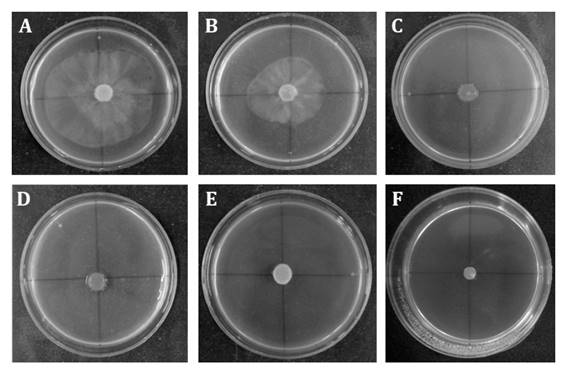

Revista de la Facultad de Ciencias
Agrarias. Universidad Nacional de Cuyo. Tomo 55(2). ISSN (en línea) 1853-8665.
Año 2023.
Original article
In
vitro and
in vivo efficacy of Larrea divaricata extract for the management
of Phytophthora palmivora in olive trees
Eficacia
in vitro e in vivo del extracto de Larrea divaricata como alternativa
de manejo de Phytophthora palmivora en plantas de olivo
María de los Ángeles Fernández1,
Magdalena Espino1,
Maria Fernanda Silva1,
Pablo Humberto Pizzuolo1,
Gabriela Susana Lucero1
1Universidad
Nacional de Cuyo. Facultad de Ciencias Agrarias. Instituto de Biología Agrícola
de Mendoza (IBAM). Consejo Nacional de Investigaciones Científicas y Técnicas
(CONICET). Almirante Brown 500. Chacras de Coria. Mendoza. M5528AHB. Argentina
*jboiteux@fca.uncu.edu.ar
Abstract
Phytophthora
palmivora is
a ubiquitous pathogen responsible for “dry branch” disease, causing significant
economic losses in olive trees. Synthetic chemical fungicides are currently used
for the control of P. palmivora. The general concern about the negative
consequences of using synthetic products prioritizes the search for
eco-friendly alternatives. In this context, plant extracts have emerged
as an interesting and promising alternative for crop protection. This work
studies the inhibitory activity of Larrea divaricata extract on P.
palmivora mycelial growth, sporangium and zoospore production. The extract
showed fungicidal activity against P. palmivora mycelial growth at
concentrations over 150 mg mL-1. Specifically, the extract at 50 mg
mL-1 completely suppressed the production of P. palmivora sporangia
and zoospores. The alkaloid piperine in L. divaricata extract showed
antimicrobial activity against P. palmivora mycelial growth. Extract
effectiveness was also evaluated on olive trees in a greenhouse, showing 63% of
disease reduction. These results support the use of L. divaricata extract
as another environmentally friendly tool to be included in an integrated disease
management program for dry branch disease caused by P. palmivora.
Keywords: plant extract, antimicrobial
activity, bioactive compounds, alkaloids, diseases, dry branch, Olea europea
Resumen
Phytophtora
palmivora es
un patógeno responsable de pérdidas económicas en olivo y está involucrado en
la enfermedad “rama seca”. Su control se basa en el uso de fungicidas. Dado el
incremento en la preocupación de la población en las consecuencias negativas
que tiene el uso de estos agroquímicos se hace prioritaria la búsqueda de
alternativas ecocompatibles. En este contexto, los extractos de plantas surgen
como una prometedora alternativa para la protección de los cultivos. En este
trabajo se estudió el efecto inhibidor in vitro del extracto de Larrea
divaricata sobre el crecimiento del micelio, la producción de zoosporangios
y zoosporas de P. palmivora. El extracto inactivó completamente el
crecimiento del micelio del patógeno a concentraciones superiores a 150 mg mL-1,
mientras que a concentraciones de 50 mg.mL-1 fue capaz de inhibir la
producción de zoosporangios y zoosporas. El alcaloide piperina fue detectado en
el extracto de L. divaricata demostrando actividad antimicrobiana. La
eficacia del extracto en plantas de olivo inoculadas con el patógeno se evaluó en
invernáculo. Este ensayo evidenció la potencialidad del extracto en el manejo
de la rama seca del olivo mostrando una eficacia del 63%. Los resultados
obtenidos respaldan el uso del extracto de L. divaricata como una
alternativa ecocompatible dentro de un programa de manejo integrado de
enfermedades de la rama seca del olivo.
Palabras claves:
extractos
vegetales, actividad antimicrobiana, compuestos bioactivos, alcaloides, enfermedades,
rama seca, Olea europea
Originales: Recepción: 26/07/2022 - Aceptación: 14/08/2023
Introduction
The genus Phytophthora
includes more than 100 species among the most destructive plant pathogens
worldwide, causing significant economic losses in agricultura (12, 17, 23, 31). P. palmivora is a
relevant species with a wide host range including pineapple, papaya, oranges,
tomatoes, tobacco, citrus, and olive trees (23).
Since the early 1990s, in the main olive growing area of Argentina, several
plants in different orchards were observed with initial drying of some branches
followed by tree death. P. palmivora, P. nicotianae and P.
citrophthora were collected from soil and roots of those symptomatic olive
tree orchards (17). After a few years,
the disease reached an important regional dissemination, with significant
losses.
Current P.
palmivora control is still based on synthetic products such as metalaxyl, fosetyl-Al,
and copper-based fungicides (21, 28, 36).
Nevertheless, these pesticides are associated with several negative
consequences for the environment and human health (6,
10). Furthermore, the extensive application of synthetic products,
such as metalaxyl, has led to the emergence of Phytophthora-resistant strains,
resulting in severe destructive disease in several crops (2, 25). Considering the aforementioned, the
search for greener and safer approaches represents an urgent need as well as a
great challenge.
In recent
decades, novel management strategies have seriously committed to environmental
and human health protection. In this context, plant extracts have emerged as an
interesting and promising alternative for crop protection. Plant extracts from Phlomis
purpurea, Cosmos caudatus, Rosmarinus officinalis, Lavandula
angustifolia, and Salvia officinalis have demonstrated an
outstanding ability to inhibit Phytophthora micelial growth, sporangium,
and zoospores production (25, 29, 33, 36).
Several plant bioactive compounds, including polyphenols, flavonoids, quinones,
tannins, alkaloids, saponins and sterols have shown antimicrobial activity
against phytopathogens (7, 26).
Larrea
divaricata Cav.
is an autochthonous dominant shrub in South America,
broadly growing in Argentina. In folk medicine, extracts of L. divaricata have
been widely used as anti-inflammatory, antirheumatic, dysphoretic, amenagogic,
and antimicrobial compounds (4). Even
though these extracts presented antimicrobial effects against Phytophthora species,
the fungicidal activity, or its efficacy as a potential protective or
curative fungicide, has not yet been reported. Phytochemical reports of our
group have demonstrated the presence of the same phenolic compounds with
antimicrobial activity previously found in L. divaricata extracts, such
as quercetin, luteolin, and cinnamic acid in L. divaricata extracts (3). However, due to the complex nature of plant
extracts, attributing antimicrobial activity to a single, specific bioactive
compound becomes difficult. Along with phenolic compounds, alkaloids are another
relevant group of active substances present in plants.
This work
studied the inhibitory activity of L. divaricata extract against P.
palmivora mycelial growth, sporangia, and zoospore production. Alkaloid
antimicrobial activity in the extract was analyzed against P. palmivora mycelial
growth. In addition, fungicidal activity of L. divaricata extract
against P. palmivora was evaluated in olive trees under greenhouse
conditions.
Material
and Methods
Materials,
chemicals, and standards solutions
V8 agar (V8A)
was prepared using 200 mL commercial V8 juice; 2 g CaCO3; 17 g agar,
and 800 mL distilled water. The salt solution of Chen and Zentmyer was prepared
by mixing Ca (NO3)2 (1.64g) (0.01 M); KNO3
(0.05g) (0.005 M); MgSO4 (0.48 g) (0.004 M); deionized H2O
to 1 liter, and a solution of chelated iron (1 mL) consisting of (g L-1)
ethylenediaminetetraacetic acid (EDTA) (13.05 g); KOH (7.5 g); FeSO4
(24.9 g) (0.16 M); and deionized water to 1 liter (2).
Analytical
standards, piperine, caffeine, harmaline, nicotine, theophylline, and
theobromine were purchased from Sigma Aldrich (St. Louis, MO, USA). Formic acid
(85%) (FA) was obtained from Sintorgan (Bs. As., Argentina). Methanol (MeOH)
and acetonitrile (ACN) of the chromatographic grade were purchased from Baker
(USA). Stock solutions were prepared by dissolving each alkaloid standard at a
concentration of 100 mg L-1 in methanol at 0.1% with FA. Standard
working solutions of each alkaloid at concentrations of 50, 25, 10, and 1 mg L-1
were obtained from stock solutions. All these solutions were stored in
dark-glass bottles at 4°C.
Plant
extract
L. divaricata plants,
taxonomically identified by Cátedra de Botánica de la Facultad de Ciencias
Agrarias de la Universidad Nacional de Cuyo (Mendoza, Argentina), were grown in
a greenhouse. Leaves were collected in the flowering period, and immediately
frozen and lyophilized.
L. divaricata extract was
prepared using the methodology proposed by Boiteux and collaborators (4). Bioactive compounds from L. divaricata leaves
(20 g) were extracted by decoction with distilled water (200 mL) in an
autoclave for 45 min at 121°C. Then the extract was filtered and the volume
reduced by boiling at 20 mL. Finally, the extract was centrifuged and stored at
4°C.
Pathogen
The P.
palmivora isolate was obtained from rotted rootlets of olive trees from
comercial plantations in the province of Catamarca, Argentina (15), and identified by morphological and
molecular characterization (17). This
isolate was maintained on clarified V8 agar.
Inhibitory
activity of L. divaricata extracts
The fungistatic
or fungicidal activity of L. divaricata extract against P. palmivora was
evaluated according to the method proposed by Mahmoudi
(2017). Agar discs (4 mm in diameter) colonized by the pathogen P.
palmivora (grown on V8 agar, 24°C, 5 days old) were placed at the center of
Petri dishes containing V8A with different concentrations of L. divaricata extract
(0; 50; 100; 150; 300; 500 and 700 mg mL-1). A positive control
using a commercial fungicide metalaxyl+mancozeb (RIDOMIL GOLD 68 WG, 4 g de
metalaxyl + 64 g de mancozeb, Syngenta) was included at the recommended
concentration (metalaxyl 0.25 mg mL-1 for Phytophthora species).
The Petri dishes were kept at 25±2°C for 4 days. After the incubation period,
discs of P. palmivora from treatments showing total inhibition were
transferred to plates containing V8A and incubated for 4 days at 25±2°C.
Fungitoxicity of each extract concentration was assessed against mycelial
growth. Thus, the plates showing P. palmivora growth indicated a
fungistatic effect, while absent growth denoted fungicidal action of the L.
divaricata extract. Each treatment was performed in triplicate and the test
was repeated three times.
Effect
of L. divaricata extract on P. palmivora sporangia and zoospores
production
The effect of L.
divaricata extract on P. palmivora sporulation was evaluated in
vitro. Petri dishes containing 6 mL of Chen and Zentmyer solutions (11) were amended with L. divaricata extract
to a final concentration of 0; 1; 5; 10; 25; 50; 100; 150; 300; 500, and 700 mg
mL-1. Subsequently, three agar discs colonized with P. palmivora mycelia
(4 mm in diameter, 5 days old) were placed in the extract solutions. A positive
chemical control, commercial fungicide metalaxyl+mancozeb was included at the
concentration described in the previous section. Each treatment was performed
in triplicate and the assay was repeated three times. Petri dishes were incubated
at 25 ± 2°C for 4 days under fluorescent cool-white light for sporangia
induction. Agar discs were stained and fixed with acid fuchsin in 85% lactic
acid. The number of sporangia per agar disk was counted using an optical
microscope (200X). Results were expressed as inhibition percentage of sporangia
production using equation 1.
Inhibition
(%)= [(C - T)/C] * 100
where:
C and T = P.
palmivora sporangia number of control (without treatment) and treatments, respectively
The effect of L.
divaricata extract on P. palmivora zoospore production was
determined after the incubation period, when the sporangium was induced to
release zoospores by chilling at 4°C for 20 min, then rewarming at 25°C for 20
min. A drop of the suspensión (5 μL) was placed on a glass slide, and zoospores
were counted using an optical microscope (200X). Each treatment was performed
in triplicate and the assay was repeated three times. Then, inhibition
percentage of zoospore production of P. palmivora was determined as follows
2:
Inhibition
(%)= [(C - T)/C] * 100
where:
C and T = the
number of P. palmivora zoospores for control (without treatment) and
treatments, respectively
Determination
of alkaloids from L. divaricata extract
Alkaloids
(theophylline, theobromine, caffeine, piperine, nicotine, and harmaline) were
determined using a HPLC-MWD system (Dionex Ultimate 3000 Softron GmbH, Thermo
Fisher Scientific Inc., Germering, Germany). The detector was a Dionex MWD-3000
(RS) model. To process the obtained data Chromeleon 7.1 software was used. HPLC
separations were carried out in Zorbax SB-Aq column (4.6 mm × 150 mm, 5 μm)
Agilent Technologies. Ultrapure water with 0.1% FA (A) and ACN (B) were used as
mobile phases. Alkaloids were separated using the following gradient: 02.7 min,
5% B; 2.710.7 min, 30% B; 10.7-11 min, 35% B; 1115 min, 50% B; 1515.5 min, 50%
B: 15.516 min 30% B; 16-16.5 min 5% B; 16.517 min 5% B. The mobile phase flow
was 1 mL min-1. The column temperature was held at 20°C and the
sample injection volume was 5 μL. Working wavelengths for the different
analytes were 254 nm, 280 nm, 320 nm, and 370 nm. Alkaloids in L. divaricata
extract were identified and quantified after the comparison of retention
times (tR) and absorbance values of detected peaks in the solvent with those
obtained by injection of pure standards of each analyte. Alkaloid concentration
was expressed as mg L-1.
Analytical
quality parameters were used to assess procedure performance with the selected
conditions. The linearity of the calibration curve was tested by plotting the
área of reference compounds at six concentrations between 0.5 mg L-1
and 100 mg L-1 using a least-squares linear regression model. For
all target compounds, correlation coefficients of calibration equations were
> 0.999.
The limit of
detection (LOD) and limit of quantitation (LOQ) were calculated following the
International Union for Pure and Applied Chemistry (IUPAC).
Antimicrobial
activity of individual alkaloids
The inhibitory
effect of individual alkaloids identified by the HPLC-MWD system in L.
divaricata extract was evaluated against P. palmivora using the
solid agar bioassay. Thus, a 4 mm disc of P. palmivora was placed in the
center of Petri dishes containing V8A amended with the alkaloids at the
concentration found in L. divaricata extract. Control plates were
performed simultaneously, in the growth medium without alkaloid. Petri dishes
were incubated at 25±2°C for 4 days. Each treatment was performed in triplicate
and the assay was repeated three times. After incubation, the P. palmivora colony
area was measured using AxioVision 4.8 software. Results were expressed as
inhibition percentage of mycelial growth using equation (3)
Inhibition
(%)= [(C - T)/C] * 100
where:
C and T = the P.
palmivora colony area (cm2) of control and treatments,
respectively
Disease
control in the bioassay
In vivo effect of L.
divaricata extract was evaluated with one-year-old olive plants (Olea
europaea L., var. Arauco) obtained from a commercial nursery. The assay was
performed following the methodology proposed by Vettraino
et al. (2009). P. palmivora inocula was prepared by mixing 20
mL millet seeds with 150 mL V8 broth in 250 mL flasks. Then, the flasks were
sterilized twice and inoculated with P. palmivora (10 mycelial discs of
8 mm diameter, grown on V8 agar per flask). The flasks were incubated for 1
month in the dark at 25°C. After incubation, millet seed inoculum (20 g L-1)
was added to the soil of olive plants. Control treatments only contained
sterile millet seeds with V8 broth (20 g L-1). To stimulate zoospore
release and disease development, pots were flooded for 48 h, then water excess
was drained off. Afterwards, L. divaricata extract was added to one
treatment, leaving control with only the extract. Experimental treatments were
as follows: (A) inoculated soil with P. palmivora and (B) inoculated
soil with P. palmivora plus L. divaricata extract at 50 mg mL-1.
Controls were performed as pathogen uninoculated soil plus L. divaricata extract
(50 mg mL-1) (C), and only soil (D). For each treatment, five
replicates were performed and the whole assay was repeated twice. The
occurrence of symptoms was observed weekly during the six months, and
percentage of dead plants was calculated at the end of the experiment. After
the assay, P. palmivora was reisolated from roots on a selective V8
medium (15).
Statistical
analysis
One-way ANOVA
was performed for in vitro and in vivo assays using InfoStat for
Windows (2020) software to determine significant differences. The Tukey test (P
< 0.05) was used for multiple comparisons of means.
Results
Inhibitory
activity of L. divaricata extracts
Interestingly,
all studied concentrations (50; 100; 150; 300; 500 and 700 mg mL-1)
reduced mycelial growth of P. palmivora. Figure 1,
shows 50 and 100 mg mL-1 extracts had a fungistatic effect, whereas
higher concentrations showed fungicidal activity.
Figure 1. Fungistatic
and fungicidal activity of L. divaricata extracts at different
concentrations (A: control; B:50; C:100; D:150; E:300;
F:500 and G:700 mg mL-1) on P. palmivora mycelial growth.
Figura 1. Efecto
fungicida y fungistático del extracto de L. divaricata a diferentes
concentraciones (A: control; B:50; C:100; D:150;
E:300; F:500 and G:700 mg mL-1) sobre el crecimiento miceliar de P.
palmivora.
Effect
of L. divaricata extract on P. palmivora sporangia and zoospores
production
Sporangia and
zoospore production of P. palmivora were inhibited by L. divaricata extract
(1; 5; 10; 25; 50; 100; 150; 300; 500 and 700 mg mL-1). Inhibition
was dose-dependent. Figure 2 shows all bioextract
concentrations were able to inhibit P. palmivora number of sporangia and
zoospores to varying degrees.
Different letters indicate significant statistical
differences according to Tukey test, α < 0.05.
Letras distintas indican diferencias significativas
para tets de Tukey, α < 0,05.
Figure 2. Effect
of L. divaricata extract on P. palmivora sporangia (A), and
zoospore production (B) at different concentrations.
Figura 2. Efecto
de diferentes concentraciones del extracto de L. divaricata sobre la
producción de zoosporangios (A) y zoosporas (B) de P. palmivora.
Interestingly,
at the lowest concentration evaluated (1 mg mL-1), the extract
inhibited 40% and 60% of sporangia and zoospore production, respectively.
Noteworthy is that 50 mg mL-1 of the extract completely suppressed
sporangia and zoospore production.
Determination
of alkaloids from L. divaricata extract
Piperine,
caffeine, harmaline, nicotine, theophylline and theobromine in L. divaricata
extract were determined by chromatographic method HPLC MWD. Table
1 shows analytical quality parameters. All of them showed a linear range
from the LOQ up to at least 100 mg L-1.
Table
1. Analytical figure of merit for alkaloids
analysis by HPLC-MWD method.
Tabla 1. Cifras
de mérito analítico para el análisis de alcaloides mediante HPLC-MWD.

tR:
retention time; Λ: wavelength; R2: coefficient of determination; LOD: limit of detection;
LOQ: limit of quantitation.
tR:
tiempo de retención; Λ: longitud de onda; R2: coeficiente de determinación; LOD:
límite de detección; LOQ: límite de cuantificación.
The only
alkaloid detected was piperine; the other five analytes were not detected,
considering the analytical methodology used. Piperine concentration was 44.02
mg mL-1.
Alkaloid
antimicrobial activity by solid agar bioassay
Since the
natural concentration of piperine in L. divaricata extract at 50 mg mL-1
was 2.20 mg mL-1, the biological activity of this alkaloid was
determined at 0.04, 2.20 and 22.01 mg mL-1. As shown in figure
3, the highest inhibition observed for piperine was 75% at 22.01 mg mL-1.
Different letters indicate significant statistical differences
according to the Tukey test, α < 0.05.
Letras distintas indican diferencias significativas para
test de Tukey, α < 0,05.
Figure 3. Effect
of piperine on P. palmivora mycelial growth at different concentrations.
Figura 3. Efecto
de diferentes concentraciones de piperina sobre el crecimiento miceliar de P.
palmivora.
Interestingly, a
10-fold lower piperine concentration (2.20 mg mL-1) achieved 42%
inhibition.
Disease
control in the greenhouse
Inoculated soil
with P. palmivora showed 73% dead plants (treatment A). When the soil
was inoculated with P. palmivora plus L. divaricata extract at 50
mg mL-1, total dead plants percentage was only 27% (treatment B) (figure 4).
Different letters indicate significant statistical
differences according to the Tukey test, α < 0.05.
Letras distintas indican diferencias significativas
entre los tratamientos según test de Tukey, α < 0,05.
Figure 4. Percentage
of dead olive plants after treatments at 120 days (A: soil infected with P.
palmivora; B: soil infected with P. palmivora plus L. divaricata extract
at 50 mg mL-1; C: soil with L. divaricata extract; D: only
soil.
Figura 4. Porcentaje
de plantas de olivo muertas después de 120 días del tratamiento (A: suelo
inoculado con P. palmivora; B: suelo inoculado con P. palmivora y
tratado con extracto de L. divaricata a una concentración de 50 mg mL-1;
C: suelo tratado con extracto de L. divaricta; D: suelo solo sin tratar
ni inocular.
These results
highlight the control potential of L. divaricata extract. Control
efficacy of the extract against P. palmivora was 63% (1). Remarkably, no significant differences were
observed between merelysoil (D) and soil containing only the extract of L.
divaricata (C). In all cases, P. palmivora was re-isolated from the
inoculated plants.
Discussion
The current
study evaluated the efficacy of L. divaricata extract for control of P.
palmivora in vitro and in olive trees under greenhouse conditions. Plant
extracts, their bioactive compounds and the ability to inhibit pathogens or
provide medicinal properties have always been of great interest to researchers.
L. divaricata extracts are a rich source of bioactive compounds against
a wide range of microorganisms (1). In
this sense, there is scarce information on the chemical composition and
antimicrobial activity of individual compounds against Phytophthora species.
A previous study by our group reported that four plant extracts showed
antimicrobial activity against P. palmivora mycelial growth, with L.
divaricata extract being the most effective (3).
However, to the best of our knowledge, the fungicidal or fungistatic effect of L.
divaricata extract against P. palmivora mycelial growth has not been
reported yet. In this work, the extract showed fungistatic effect at a
concentration between 50 and 100 mg mL-1, and fungicidal effect
between 150 and 700 mg mL-1.
Different
studies have reported the fungicidal activity of L. divaricata extracts
against different pathogen species. Vogt et al.
(2013) studied the efficacy of L. divaricata organic extracts
against Fusarium graminearum, F. solani, F. verticillioides and
Macrophomina phaseolina. F. graminearum and M. phaseolina were
completely inhibited at 0.25 mg mL-1 of L. divaricata chloroform
extract (33). Hapon
et al. (2017) demonstrated that 200 mg mL-1 of L.
divaricata extract inhibited mycelial growth of Botrytis cinerea (94%)
(13). Interestingly, in this work, a
considerably lower concentration of L. divaricata extract was able to
completely inhibit P. palmivora growth.
The asexual
stages, including sporangia and zoospore, are the main propagules involved in
the rapid spread of P. palmivora. Therefore, evaluating the efficacy of
extracts in controlling these asexual structures is of utmost importance.
Particularly, in our study, L. divaricata extract showed inhibitory
activity on both sporangia formation and zoospore production of P. palmivora.
Salehan et al. (2013) reported that Cosmos
caudatus aqueous extract at 200 mg mL-1 inhibited 37% sporangia
formation and 23% zoospore production of P. palmivora (29). Widmer and Laurent
(2006) demonstrated that plant extracts of Rosmarinus officinalis, Lavandula
angustifolia and Salvia officinalis at 250 mg mL-1 were able
to inhibit zoospore production of P. capsici, P. megakarya and P.
palmivora (35). In line with these
studies, our results also highlight the efficacy of L. divaricata extract
in inhibiting sporangia and zoospore production of P. palmivora.
In view of the
above, L. divaricata extract represents a great alternative for the in
vitro control of P. palmivora. Noteworthy is that the antimicrobial
activity of L. divaricata extract has been related with the presence of
phenolic compounds (3). In this study,
piperine was the only alkaloid found in the extract by HPLC-MWD analysis. This
alkaloid is a bioactive component with outstanding biological properties such
as antitumoral, anti-inflammatory, antifungal and antimicrobial (14, 20, 30).
Several studies
have documented the antibacterial activity of piperine against Escherichia
coli, Klebsiella pneumonia, Salmonella enterica, Staphylococcus
aureus, S. epidermidis, Enterococcus faecalis and Bacillus
subtilis (9, 16, 22, 27, 37). Marques et al. (2010) reported antifungal
activity of this compound against Cladosporium cladosporioides and C.
sphaerospermum (19). Moon et al. (2016) demonstrated that piperine
inhibited mycelial growth and aflatoxin production of Aspergillus flavus (24). Wang et al.
(2020) demonstrated the fungicidal activity of piperine against Rhizoctonia
solani, Fusarium graminearum, Phomopsis adianticola, Alternaria
tenuis, Phytophthora capsici and Gloeosporium theaesinensis.
Piperine at 0.1 mg mL-1 inhibited mycelial growth of P. capsici at
42% (35). These results agree with those
presented in this work, where piperine at 2.20 mg mL-1 inhibited P.
palmivora mycelial growth by 42 %. To the best of our knowledge, this
constitutes the first report on antimicrobial activity of piperine against P.
palmivora. Interestingly, we found that the inhibitory activity of L.
divaricata extract against P. palmivora was higher than piperine used
at the same concentration. This results indicate that piperine could partially
explain extrat total bioactivity against this pathogen. Unfortunately, no
studies have used piperine in the concentration range tested in our study
against P. palmivora. Considering that plant extracts are complex
matrices, it is logical to assume that different compounds of L. divaricata secondary
metabolism, could be active against several plant pathogens.
As seen in our in
vitro studies, the extract was also effective when the biological activity
was assessed on healthy olive plants artificially inoculated with P.
palmivora under greenhouse conditions. In the latter case, the number of
dead plants was significantly reduced compared to non-inoculated plants.
Previous studies have also demonstrated the efficacy of plant extracts in
controlling soilborne pathogens (5, 34). Bowers et al. (2004) showed that synthetic
cinnamon oil, pepper and cassia extracts reduced P. nicotianae populations
on infected Catharanthus roseus (L.) plants under greenhouse conditions
(5). Wang et
al. (2019) demonstrated that zedoary turmeric oil has excellent
antifungal activity against P. capsica, inoculated on detached cucumber
leaves (34). These results are consistent
with those presented in this work, where L. divaricata extract showed
control activity against P. palmivora in olive plants.
Conclusion
This work
highlights the potential of L. divaricata extract for sustainable
management of P. palmivora. The extract obtained had an effective
inhibitory activity on mycelial growth, sporangia and zoospore production of
this pathogen. We also demonstrated that the presence of the alkaloid piperine
in the extract, together with other phenolic compounds, contributes to
antimicrobial activity. These results support the use of L. divaricata extract
as another environmentally friendly tool for an integrated disease management
programme against dry branch disease caused by P. palmivora. Further
complementary studies are required to evaluate commercial applications and
effects on beneficial soil organisms.
Acknowledgements
The authors
thank the Agencia Nacional de Promoción Científica y Tecnológica, Consejo
Nacional de Investigaciones Científicas y Técnicas (CONICET), Facultad de
Ciencias Agrarias- Universidad Nacional de Cuyo and Secretaría de
Investigación, Internacionales y Posgrado (SIIP)- Universidad Nacional de Cuyo
for the financial support of this work.
1. Abbott, W. S.
1925. A method of computing the effectiveness of an insecticide. Journal of
Economic Entomology. 18: 265-267.
2. Bi, Y.; Cui,
X.; Lu, X.; Cai, M.; Liu, X.; Hao, J. J. 2011. Baseline sensitivity of natural
population and resistance of mutants in Phytophthora capsici to
zoxamide. Phytopathology. 101: 1104-1111.
3. Boiteux, J.;
Vargas, C. S.; Pizzuolo, P.; Lucero, G.; Silva, M. F. 2014. Phenolic
characterization and antimicrobial activity of folk medicinal plant extracts
for their applications in olive production. Electrophoresis. 35: 1709-1718.
4. Boiteux, J.;
Monardez, C.; Fernandez, M. A.; Espino, M.; Pizzuolo, P.; Silva, M. F. 2018. Larrea
divaricata volatilome and antimicrobial activity against Monilinia
fructicola. Microchemical Journal. 142: 1-8.
5. Bowers, J.
H.; J. Locke, C. 2004. Effect of formulated plant extracts and oils on
population density of Phytophthora nicotianae in soil and control of Phytophthora
blight in the greenhouse. Plant disease. 88: 11-16.
6. Céspedes, C.
L.; Alarcon J. E.; Aqueveque, P.; Seigler, D. S.; Kubo, I. 2015. In the search
for new secondary metabolites with biopesticidal properties. Israel Journal of
Plant Sciences. 62: 216-228.
7. Chen, F.;
Long, X.; Yu, M.; Liu, Z.; Liu, L.; Shao, H. 2013. Phenolics and antifungal
activities analysis in industrial crop Jerusalem artichoke (Helianthus
tuberosus L.) leaves. Industrial Crops and Products. 47: 339-345.
8. Di Rienzo, J.
A.; Casanoves, F.; Balzarini, M. G.; Gonzalez, L.; Tablada, M.; Robledo, C. W.
InfoStat versión 2020. Centro de Transferencia InfoStat, FCA. Universidad
Nacional de Córdoba. Argentina. http://www.infostat.com.ar
9. Dusane, D.
H.; Hosseinidoust, Z.; Asadishad, B.; Tufenkji, N. 2014. Alkaloids modulate
motility, biofilm formation and antibiotic susceptibility of uropathogenic Escherichia
coli. PLoS ONE, 9.
10. El-Sayed, A.
S.; Ali, G. S. 2020. Aspergillus flavipes is a novel efficient
biocontrol agent of Phytophthora parasitica. Biological Control. 140:
104072.
11. Erwin, D.;
Ribeiro, O. 1996. Phytophthora Diseases Worldwide: American
Phytopathological Society 1996. St. Paul. MN. USA.
12. González,
M.; Perez‐Sierra, A.; Serrano, M.; Sánchez, M. 2017. Two Phytophthora species
causing decline of wild olive (Olea europaea subsp. europaea var. sylvestris).
Plant pathology. 66: 941-948.
13. Hapon, M.
V.; Boiteux, J. J.; Fernández, M.; Lucero, G.; Silva, M. F.; Pizzuolo, P. H.
2018. Effect of phenolic compounds present in Argentinian plant extracts on
mycelial growth of the plant pathogen Botrytis cinerea Pers.
14. Hou, X.-F.;
Pan, H.; Xu, L.-H.; Zha, Q.-B.; He, X.-H.; Ouyang, D. Y. 2015. Piperine
suppresses the expression of CXCL8 in lipopolysaccharide-activated SW480 and
HT-29 cells via downregulating the mitogen-activated protein kinase pathways.
Inflammation. 38: 1093-1102.
15. Jung, T.;
Blaschke, H.; Neumann, P. 1996. Isolation, identification and pathogenicity of Phytophthora
species from declining oak stands. European Journal of Forest Pathology.
26: 253-272.
16. Khameneh,
B.; Iranshahy, M.; Ghandadi, M.; Ghoochi Atashbeyk, D.; Fazly Bazzaz, B. S.;
Iranshahi, M. 2015. Investigation of the antibacterial activity and efflux pump
inhibitory effect of co-loaded piperine and gentamicin nanoliposomes in
methicillin-resistant Staphylococcus aureus. Drug development and
industrial pharmacy. 41: 989-994.
17. Lucero, G.;
Vettraino, A.; Pizzuolo, P.; Stefano, C. D.; Vannini, A. 2007. First report of Phytophthora
palmivora on olive trees in Argentina. Plant pathology. 56.
18. Mahmoudi, E.
2017. Antifungal effects of Foeniculum vulgare Mill. Herb essential oil
on the phenotypical characterizations of Alternaria alternata Kessel.
Journal of Essential Oil Bearing Plants. 20: 583-590.
19. Marques, J.
V.; de Oliveira, A.; Raggi, L.; Young, M. C. M.; Kato, M. J. 2010. Antifungal
activity of natural and synthetic amides from Piper species. Journal of
the Brazilian Chemical Society. 21: 1807-1813.
20.
Martinez-Sena, M. T.; de la Guardia, M. F.; Esteve-Turrillas, A.; Armenta, S.
2017. Hard cap espresso extraction and liquid chromatography determination of
bioactive compounds in vegetables and spices. Food chemistry. 237: 75-82.
21. McLeod, A.;
Masikane, S. L.; Novela, P.; Ma, J.; Mohale, P.; Nyoni, M.; Stander, M.;
Wessels, J.; Pieterse, P. 2018. Quantification of root phosphite concentrations
for evaluating the potential of foliar phosphonate sprays for the management of
avocado root rot. Crop protection. 103: 87-97.
22. Mirza, Z.
M.; Kumar, A.; Kalia, N. P.; Zargar, A.; Khan, I. A. 2011. Piperine as an
inhibitor of the MdeA efflux pump of Staphylococcus aureus. Journal of
medical microbiology. 60: 1472-1478.
23. Mohamed
Azni, I. N. A.; Sundram, S.; Ramachandran, V.; Seman, Abu I. 2017. An in
vitro investigation of Malaysian Phytophthora palmivora isolates and
pathogenicity study on oil palm. Journal of Phytopathology. 165: 800-812.
24. Moon, Y.-S.;
Choi, W.-S.; Park, E.-S.; Bae, I. K.; Choi, S.-D.; Paek, O., S.; Kim, H.; Chun,
H. S.; Lee, S. E. 2016. Antifungal and antiaflatoxigenic
methylenedioxy-containing compounds and piperine-like synthetic compounds.
Toxins. 8: 240.
25. Neves, D.;
Caetano, P.; Oliveira, J.; Maia, C.; Horta, M.; Sousa, N.; Salgado, M.;
Dionísio, L.; Magan, N.; Cravador, A. 2014. Anti-Phytophthora cinnamomi activity
of Phlomis purpurea plant and root extracts. European journal of plant
pathology. 138: 835-846.
26. Piccirillo,
C.; Demiray, S.; Silva Ferreira, A. C.; Pintado, M. E.; Castro, P. M. L. 2013.
Chemical composition and antibacterial properties of stem and leaf extracts
from Ginja cherry plant. Industrial Crops and Products. 43: 562-569.
27. Quijia, C.
R.; Chorilli, M. 2020. Characteristics, biological properties and analytical
methods of piperine: A review. Critical reviews in analytical chemistry. 50:
62-77.
28. Rodrigo, S.;
Santamaria, O.; Halecker, S.; Lledó, S.; Stadler, M. 2017. Antagonism between Byssochlamys
spectabilis (anamorph Paecilomyces variotii) and plant pathogens:
Involvement of the bioactive compounds produced by the endophyte. Annals of
Applied Biology. 171: 464-476.
29. Salehan, N.
M.; Meon, S.; Ismail, I. S. 2013. Antifungal activity of Cosmos caudatus extracts
against seven economically important plant pathogens. International Journal of
Agriculture and Biology. 15.
30.
Tharmalingam, N.; Kim, S.-H.; Park, M.; Woo, H. J.; Kim, H. W.; Yang, J. Y.;
Rhee, K.-J.; Kim, J. B. 2014. Inhibitory effect of piperine on Helicobacter
pylori growth and adhesion to gastric adenocarcinoma cells. Infectious
agents and cancer. 9: 43.
31. Tomura, T.;
Molli, S. D.; Murata, R.; Ojika, M. 2017. Universality of the Phytophthora mating
hormones and diversity of their production profile. Scientific reports. 7:
1-12.
32. Vettraino,
A.; Lucero, G.; Pizzuolo, P.; Franceschini, S.; Vannini, A. 2009. First report
of root rot and twigs wilting of olive trees in Argentina caused by Phytophthora
nicotianae. Plant disease. 93: 765-765.
33. Vogt, V.;
Cifuente, D.; Tonn, C.; Sabini, L.; Rosas, S. 2013. Antifungal activity in
vitro and in vivo of extracts and lignans isolated from Larrea
divaricata Cav. against phytopathogenic fungus.
Industrial crops and products. 42: 583-586.
34. Wang, B.;
Liu, F.; Li, Q.; Xu, S.; Zhao, X.; Xue, P.; Feng, X. 2019. Antifungal activity
of zedoary turmeric oil against Phytophthora capsici through damaging
cell membrane. Pesticide biochemistry and physiology. 159: 59-67.
35. Wang, J.;
Wang, W.; Xiong, H.; Song, D.; Cao, X. 2020. Natural phenolic derivatives based
on piperine scaffold as potential antifungal agents. BMC chemistry. 14(1):
1-12.
36. Widmer, T.
L.; Laurent, N. 2006. Plant extracts containing caffeic acid and rosmarinic
acid inhibit zoospore germination of Phytophthora spp. pathogenic to Theobroma cacao. European Journal of
plant pathology. 115: 377.
37. Zarai, Z.;
Boujelbene, E.; Salem, N. B.; Gargouri, Y.; Sayari, A. 2013. Antioxidant and
antimicrobial activities of various solvent extracts, piperine and piperic acid
from Piper nigrum. Lwt-Food science and technology. 50: 634-641.